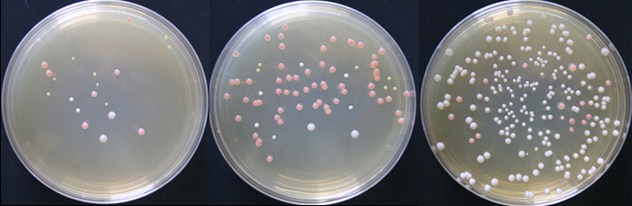

Laboratorio de Microbiología Enológica |
 |
| Inicio | Historia | Equipos | Formación | Proyectos y convenios I+D+I | Publicaciones científicas |
Servicios |
Breve resumen
Enolab fue creado hace aproximadamente 30 años por el Catedrático Sergi Ferrer junto con la Catedrática Isabel Pardo. Desde el principio la finalidad del laboratorio es la investigación en microorganismos y el trabajo se lleva a cabo gracias a la financiación recibida tanto pública como privada, dando lugar a grandes proyectos científicos y a la publicación de gran número de artículos científicos, así como la participación en congresos y conferencias.
En
la década
de los 80 se comienzan a utilizar sistemas clásicos de identificación y
tipificación de microorganismos, concretamente levaduras y Bacterias
Lácticas y en los años 90 comenzamos a aplicar
técnicas
moleculares para
esta finalidad, desarrollando nuevos métodos y sistemas que facilitan y
agilizan los análisis, al tiempo que son más potentes e informativos
que los
anteriores.
Hemos diseñado cebadores de PCR y secuenciación de levaduras, Bacterias Lácticas y bacterias acéticas para identificar, tipificar o detectar genes de interés tecnológico, sondas de hibridación DNA-DNA, sobre todo para FISH (Fluorescence In Situ Hybridization), y sondas específicas para desarrollar un nanochip electrónico que permite detectar unas 45 especies simultáneamente en una misma muestra de vino.
El
total de
secuencias oligonucleotídicas diseñadas para ser empleadas con las
distintas
técnicas por el grupo hasta el momento supera las trescientas, y siguen
aumentando. También se ha desarrollado un nuevo método que permite
diferenciar
entre células vivas y muertas mediante técnicas de PCR en células
enteras, sin
necesidad de realizar extracciones de DNA.
Habitualmente
empleamos en nuestro laboratorio sistemas de tinción fluorescente para
observar
por microscopía el estado de viabilidad de levaduras y bacterias. Son
sistemas
rápidos, fáciles de realizar y de bajo coste que precisan de poco
equipamiento.
Varias de estas técnicas desarrolladas, todas ellas publicadas o en
fase de
escritura de los artículos científicos, han sido transferidas a algunas
empresas del sector enológico, y en nuestro laboratorio
realizamos el
entrenamiento del personal técnico de las mismas.
Entre otros resultados, el desarrollo de estas técnicas moleculares ha permitido realizar el seguimiento de cultivos iniciadores inoculados, control microbiológico de filtración y embotellado, detección precoz de posibles alteraciones, control de fraudes, estudio de la dinámica de especies microbianas, etc. También han posibilitado la descripción de 4 nuevas especies de Bacterias Lácticas aisladas de vinos y nuevas citas de Bacterias Lácticas y Bacterias Acéticas no encontrados antes en vinos. Contamos con nuevos aislados, tanto de Bacterias Lácticas como de Bacterias Acéticas, candidatos para constituir nuevas especies de próximas descripción.
Tenemos experiencia en el aislamiento y caracterización de Bacterias Lácticas del vino, así como de su empleo en procesos de acidificación biológica, habiendo participado en varios proyectos científicos relacionados. Ello permite ofrecer una base científica y de formación adecuada.
| Contacto |
2012. Página creada por Noelia Barrachina